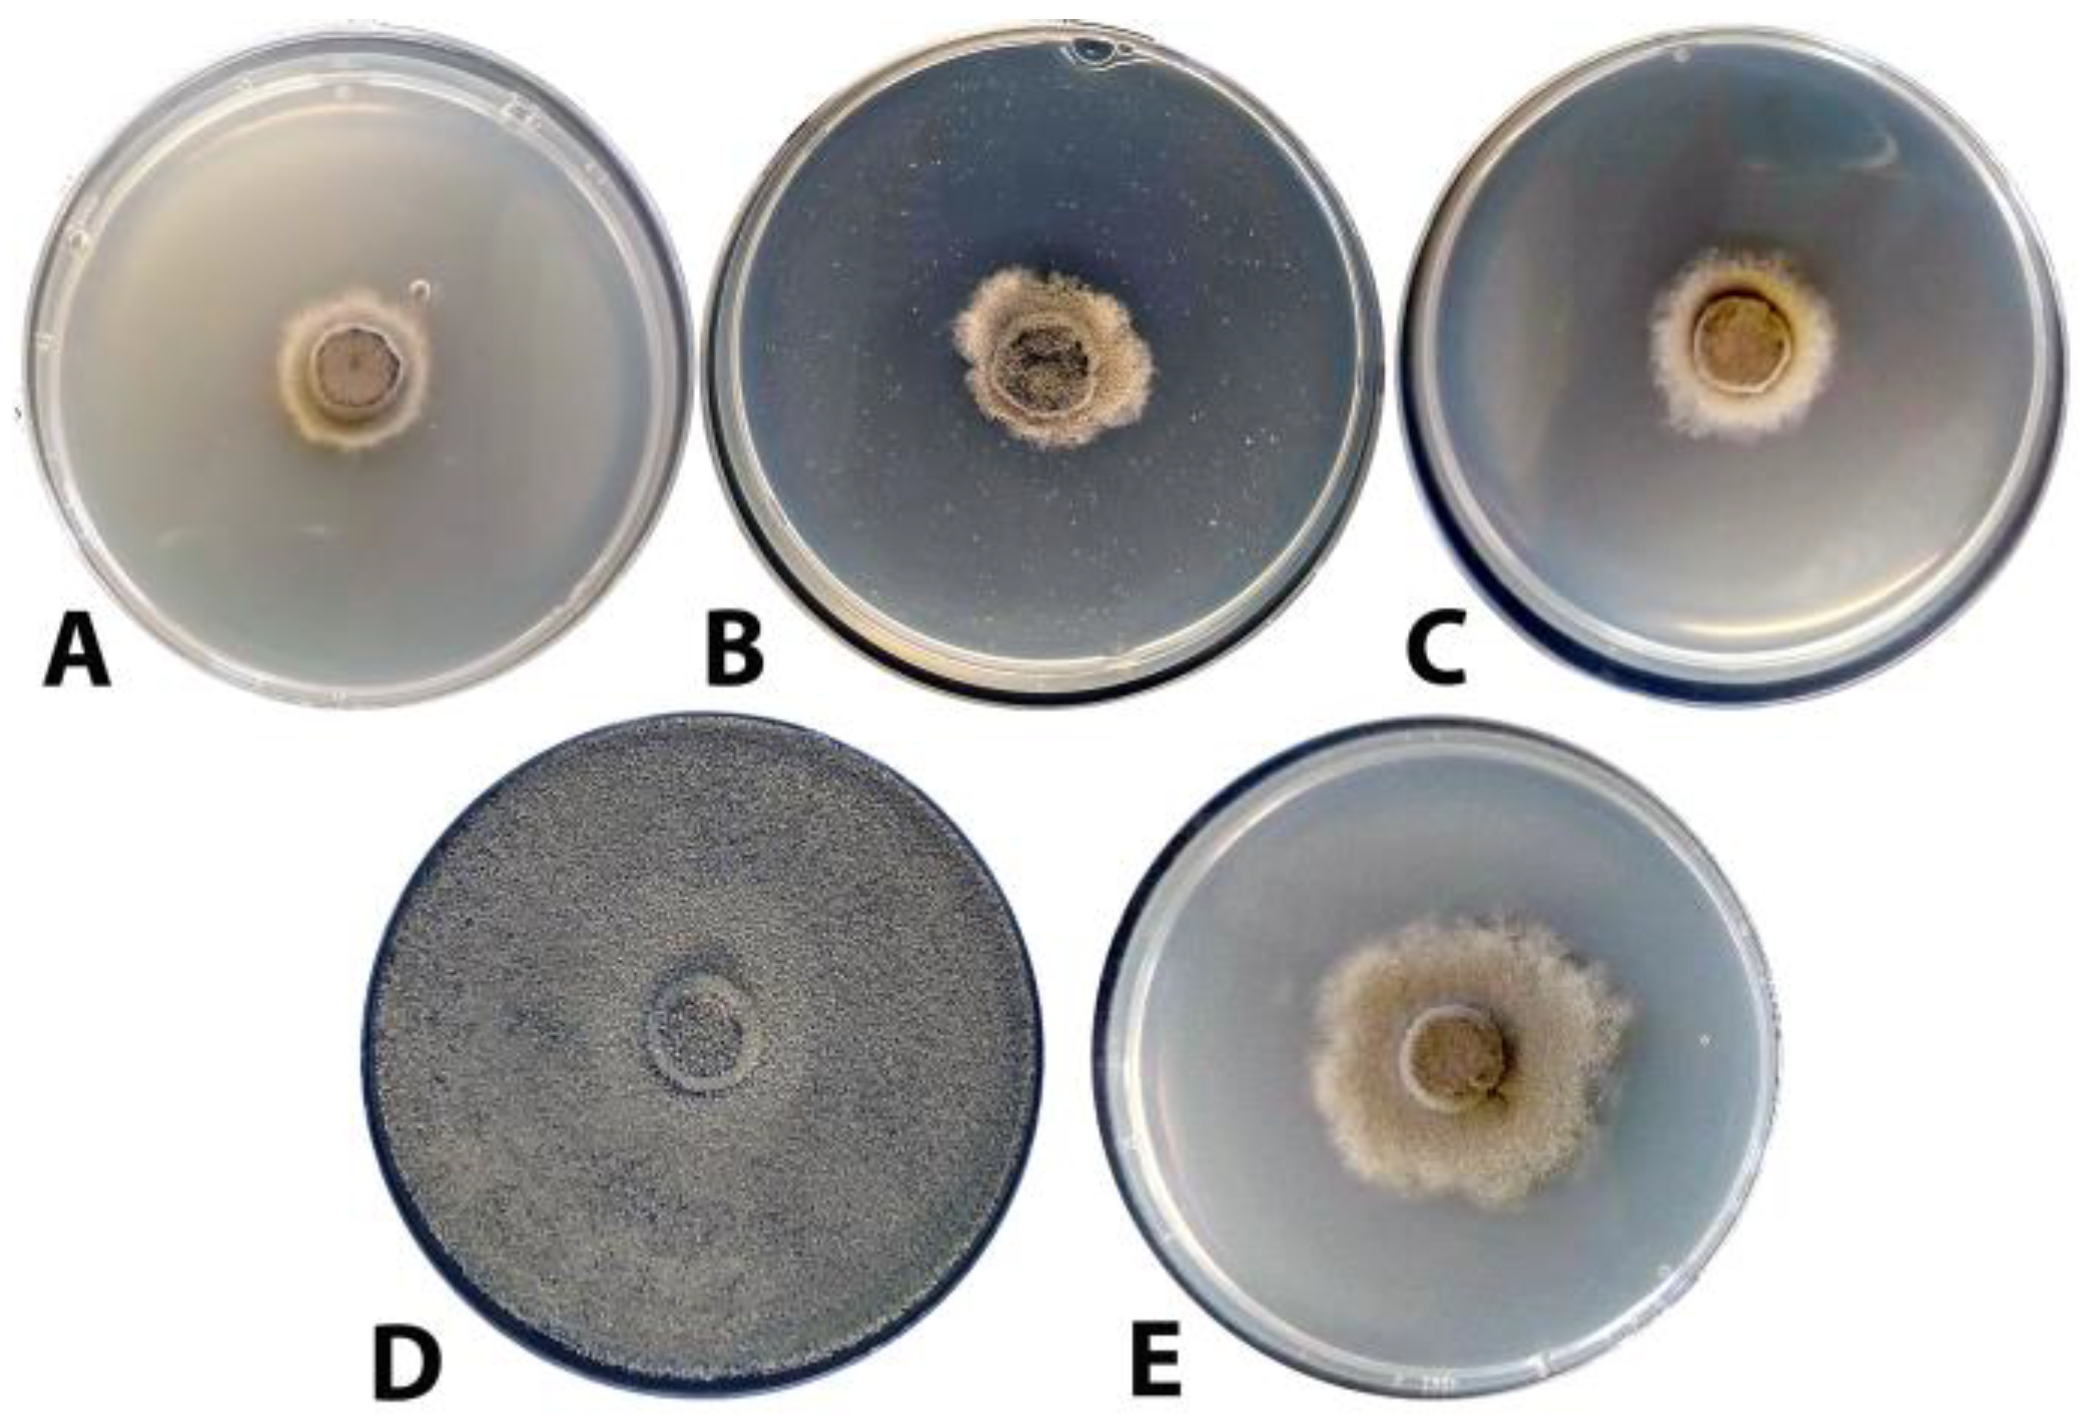
Agronomy 13 02602 g008

Inhibition of the Growth of Botrytis cinerea by Penicillium chrysogenum VKM F-4876D Combined with Fludioxonil-, Difenoconazole-, or Tebuconazole-Based Fungicides
Abstract
:1. Introduction
2. Materials and Methods
2.1. Reagents
2.2. Microorganisms
2.3. Isolation and Identification of Botrytis cinerea
2.4. Composition of Nutrient Media for Cultivation and Maintenance of Penicillium chrysogenum and Botrytis cinerea
2.5. Cultivation of Penicillium chrysogenum F-4876D in Liquid Medium and Obtaining of Dry Mycelial Biomass (DMP)
2.6. Evaluation of the Antagonistic Activity by a Dual Culture Assay
2.7. Preparation of Agar Medium Supplemented with DMP Suspension
2.8. Preparation of Agar Medium Supplemented with Fungicides
2.9. Evaluation of the Antifungal Activity of DMP by a Radial Growth Method
2.10. Evaluation of the DMP Effect on the Conidial Germination of Botrytis cinerea
2.11. Inhibition of Botrytis cinerea Development on Injured Grape Berries in the Presence of DMP
2.12. Data Treatment
3. Results
3.1. Identification of Isolated Botrytis cinerea
3.2. Evaluation of the Antagonistic Activity of F-4876D towards Botrytis cinerea
3.3. Antifungal Activity of DMP towards Botrytis cinerea
3.4. Effect of DMP on Conidial Germination in Botrytis cinerea
3.5. Evaluation of the Antifungal Activity of Fungicides (Difenoconazole, Tebuconazole, and Fludioxonyl) against B. cinerea
3.6. Antifungal Activity of DMP Combined with Different Fungicides against B. cinerea
3.7. Inhibition of Botrytis cinerea Growth on Grape Berries
4. Discussion
5. Conclusions
Supplementary Materials
Author Contributions
Funding
Institutional Review Board Statement
Data Availability Statement
Conflicts of Interest
References
- Dean, R.; Van Kan, J.A.L.; Pretorius, Z.A.; Hammond-Kosack, K.E.; Di Pietro, A.; Spanu, P.D.; Rudd, J.J.; Dickman, M.; Kahmann, R.; Ellis, J.; et al. The Top 10 fungal pathogens in molecular plant pathology. Mol. Plant Pathol. 2016, 13, 414–430. [Google Scholar] [CrossRef]
- Elad, Y.; Pertot, I.; Cotes, A.M.; Stewart, A. Plant hosts of Botrytis spp. In Botrytis—The Fungus, the Pathogen and Its Management in Agricultural Systems; Fillinger, S., Elad, Y., Eds.; Springer International Publishing: Cham, Switzerland, 2016; pp. 413–486. [Google Scholar]
- Zhou, Y.; Song, J.; Wang, Y.; Yang, L.; Wu, M.; Li, G.; Zhang, J. Biological characterization of the melanin biosynthesis gene Bcscd1 in the plant pathogenic fungus Botrytis cinerea. Fungal Genet. Biol. 2022, 160, 103693. [Google Scholar] [CrossRef]
- Fernandez-San Millan, A.; Gamir, J.; Larraya, L.; Farran, I.; Veramendi, J. Towards understanding of fungal biocontrol mechanisms of different yeasts antagonistic to Botrytis cinerea through exometabolomic analysis. Biol. Control 2022, 174, 105033. [Google Scholar]
- Bi, K.; Liang, Y.; Mengiste, T.; Sharon, A. Killing softly: A roadmap of Botrytis cinerea pathogenicity. Trends Plant Sci. 2023, 28, 211–222. [Google Scholar] [CrossRef]
- Derbyshire, M.C.; Newman, T.E.; Khentry, Y.; Owolabi Taiwo, A. The evolutionary and molecular features of the broad-host-range plant pathogen Sclerotinia sclerotiorum. Mol. Plant Pathol. 2022, 23, 1075–1090. [Google Scholar] [CrossRef]
- Cheung, N.; Tian, L.; Liu, X.; Li, X. The destructive fungal pathogen Botrytis cinerea—Insights from genes studied with mutant analysis. Pathogens 2020, 9, 923. [Google Scholar] [CrossRef]
- Abu Qamar, S.; Moustafa, K.; Tran, L.S. Mechanisms and strategies of plant defense against Botrytis cinerea. Crit. Rev. Biotechnol. 2017, 37, 262–274. [Google Scholar] [CrossRef]
- Samaras, A.; Karaoglanidis, G.S.; Tzelepis, G. Insights into the multitrophic interactions between the biocontrol agent Bacillus subtilis MBI 600, the pathogen Botrytis cinerea and their plant host. Microbiol. Res. 2021, 248, 126752. [Google Scholar] [CrossRef]
- Abu Qamar, S.F.; Moustafa, K.; Tran, L.S. “Omics” and plant responses to Botrytis cinerea. Front. Plant Sci. 2016, 7, 1658. [Google Scholar]
- Williamson, B.; Tudzynski, B.; Tudzynski, P.; van Kan, J.A. Botrytis cinerea: The cause of grey mould disease. Mol. Plant Pathol. 2007, 8, 561–580. [Google Scholar] [CrossRef]
- Schumacher, J. How light affects the life of Botrytis. Fungal Gen. Biol. 2017, 106, 26–41. [Google Scholar] [CrossRef] [PubMed]
- Xiong, F.; Liu, M.; Zhuo, F.; Yin, H.; Deng, K.; Feng, S.; Liu, Y.; Luo, X.; Li, F.; Zhang, S.; et al. Host-induced gene silencing of BcTOR in Botrytis cinerea enhances plant resistance to grey mould. Mol. Plant Pathol. 2019, 20, 1722–1739. [Google Scholar] [CrossRef] [PubMed]
- Cosseboom, S.D.; Schnabel, G.; Hu, M. Competitive ability of multi-fungicide resistant Botrytis cinerea in a blackberry planting over three years. Pest. Biochem. Physiol. 2020, 163, 1–7. [Google Scholar] [CrossRef] [PubMed]
- Li, T.; Li, H.; Liu, T.; Zhu, J.; Lanyun, Z.; Wei, M.; Feng, L. Evaluation of the antifungal and biochemical activities of mefentrifluconazole against Botrytis cinerea. Pest. Biochem. Physiol. 2021, 173, 104784. [Google Scholar] [CrossRef]
- Calvo-Garrido, C.; Roudet, J.; Aveline, N.; Davidou, L.; Dupin, S.; Fermaud, M. Microbial antagonism toward Botrytis bunch rot of grapes in multiple field tests using one Bacillus ginsengihumi strain and formulated biological control products. Front. Plant Sci. 2019, 10, 105. [Google Scholar] [CrossRef]
- Shao, W.; Zhao, Y.; Ma, Z. Advances in understanding fungicide resistance in Botrytis cinerea in China. Phytopathology® 2021, 111, 455–463. [Google Scholar] [CrossRef]
- Bello, F.; Montironi, I.D.; Medina, M.B.; Munitz, M.S.; Ferreira, F.V.; Williman, C.; Vázquez, D.; Cariddi, L.N.; Musumeci, M.A. Mycofumigation of postharvest blueberries with volatile compounds from Trichoderma atroviride IC-11 is a promising tool to control rots caused by Botrytis cinerea. Food Microbiol. 2022, 106, 104040. [Google Scholar] [CrossRef]
- Srivastava, D.A.; Harris, R.; Breuer, G.; Levy, M. Secretion-based modes of action of biocontrol agents with a focus on Pseudozyma aphidis. Plants 2021, 10, 210. [Google Scholar] [CrossRef]
- Zhang, Y.; Li, S.; Deng, M.; Gui, R.; Liu, Y.; Chen, X.; Lin, Y.; Li, M.; Wang, Y.; He, W.; et al. Blue light combined with salicylic acid treatment maintained the postharvest quality of strawberry fruit during refrigerated storage. Food Chem. X 2022, 15, 100384. [Google Scholar] [CrossRef]
- Rather, I.A.; Koh, W.Y.; Paek, W.K.; Lim, J. The sources of chemical contaminants in food and their health implications. Front. Pharm. 2017, 8, 830. [Google Scholar] [CrossRef]
- Wang, Y.; Qiao, Y.; Zhang, M.; Ma, Z.; Xue, Y.; Mi, Q.; Wang, A.; Feng, J. Potential value of small-molecule organic acids for the control of postharvest gray mold caused by Botrytis cinerea. Pest. Biochem. Physiol. 2021, 177, 104884. [Google Scholar] [CrossRef] [PubMed]
- Pérez-García, A.; Romero, D.; Vicente, A. Plant protection and growth stimulation by microorganisms: Biotechnological applications of Bacilli in agriculture. Curr. Opin. Biotechnol. 2011, 22, 187–193. [Google Scholar] [CrossRef]
- Stein, T. Bacillus subtilis antibiotics: Structures, syntheses and specific functions. Mol. Microbiol. 2005, 56, 845–857. [Google Scholar] [CrossRef] [PubMed]
- Ma, H.-G.; Liu, Q.; Zhu, G.-L.; Liu, H.-S.; Zhu, W.-M. Marine natural products sourced from marine-derived Penicillium fungi. J. Asian Nat. Prod. Res. 2016, 18, 92–115. [Google Scholar] [CrossRef] [PubMed]
- Huber, A.; Galgoczy, L.; Varadi, G.; Holzknecht, J.; Kakar, A.; Malanovic, N.; Leber, R.; Kochf, J.; Kellerf, M.A.; Battag, G.; et al. Two small, cysteine-rich and cationic antifungal proteins from Penicillium chrysogenum: A comparative study of PAF and PAFB. BBA Biomembr. 2020, 1862, 183246. [Google Scholar] [CrossRef] [PubMed]
- Li, J.; Wu, Z.; Zhu, Z.; Xu, L.; Wu, B.; Li, J. Botrytis cinerea mediated cell wall degradation accelerates spike stalk browning in Munage grape. J. Food Biochem. 2022, 46, e14271. [Google Scholar] [CrossRef]
- Xu, D.; Xue, M.; Shen, Z.; Jia, X.; Hou, X.; Lai, D.; Zhou, L. Phytotoxic secondary metabolites from fungi. Toxins 2021, 13, 261. [Google Scholar] [CrossRef]
- Dzhavakhiya, V.; Shcherbakova, L.; Semina, Y.; Zhemchuzhina, N.; Campbell, B. Chemosensitization of plant pathogenic fungi to agricultural fungicides. Front. Microbiol. 2012, 3, 87. [Google Scholar] [CrossRef]
- Kim, K.; Lee, Y.; Ha, A.; Kim, J.-I.; Park, A.R.; Yu, N.H.; Son, H.; Choi, G.J.; Woong Park, H.; Lee, C.W.; et al. Chemosensitization of Fusarium graminearum to chemical fungicides using cyclic lipopeptides produced by Bacillus amyloliquefaciens Strain JCK-12. Front. Plant Sci. 2017, 8, 2010. [Google Scholar] [CrossRef]
- Karpova, N.V.; Yaderets, V.V.; Glagoleva, E.V.; Petrova, K.S.; Ovchinnikov, A.I.; Dzhavakhiya, V.V. Antifungal activity of the dry biomass of Penicillium chrysogenum F-24-28 and is application in combination with azoxystrobin for efficient crop protection. Agriculture 2021, 11, 935. [Google Scholar] [CrossRef]
- Jarvis, W.R. Botryotinia and Botrytis Species: Taxonomy, Physiology, and Pathogenicity: A Guide to the Literature; Monograph 15; Canada Department of Agriculture: Ottawa, ON, Canada, 1977. [Google Scholar]
- Tenberge, K.B. Morphology and cellular organisation in Botrytis interactions with plants. In Botrytis: Biology, Pathology and Control; Elad, Y., Williamson, B., Tudzynski, P., Delen, N., Eds.; Springer: Dordrecht, The Netherlands, 2007; pp. 67–84. [Google Scholar]
- Bulygina, E.S.; Kuznetsov, B.B.; Marusina, A.I.; Kravchenko, I.K.; Bykova, S.A.; Kolganova, T.V.; Galchenko, V.F. Study of nucleotide sequences of nifH genes in methanotrophic bacteria. Microbiologiia 2002, 71, 425–432. [Google Scholar]
- Sanger, F.; Nicklen, S.; Coulson, A.R. DNA sequencing with chain-terminating inhibitors. Proc. Natl. Acad. Sci. USA 1977, 84, 5463–5467. [Google Scholar] [CrossRef] [PubMed]
- Richer, D.L. Synergism: A patent view. Pestic. Sci. 1987, 19, 309–315. [Google Scholar] [CrossRef]
- Finney, D.J. Probit Analysis; Cambridge University Press: New York, NY, USA, 1952; p. 256. [Google Scholar]
- Bleve, G.; Grieco, F.; Cozzi, G.; Logrieco, A.; Visconti, A. Isolation of epiphytic yeasts with potential for biocontrol of Aspergillus carbonarius and A. niger on grape. Int. J. Food Microbiol. 2006, 108, 204–209. [Google Scholar] [CrossRef]
- Zhang, C.; Imran, M.; Xiao, L.; Hu, Z.; Li, G.; Zhang, F.; Liu, X. Difenoconazole resistance shift in Botrytis cinerea from tomato in China associated with inducible expression of CYP51. Plant Dis. 2021, 105, 400–407. [Google Scholar] [CrossRef] [PubMed]
- Zhang, C.; Li, T.; Xiao, L.; Zhou, S.; Liu, X. Characterization of tebuconazole resistance in Botrytis cinerea from tomato plants in China. Phytopathol. Res. 2020, 2, 25. [Google Scholar] [CrossRef]
- Rupp, S.; Weber, R.W.; Rieger, D.; Detzel, P.; Hahn, M. Spread of Botrytis cinerea strains with multiple fungicide resistance in German horticulture. Front. Microbiol. 2017, 7, 2075. [Google Scholar] [CrossRef]
- Kozlovskii, A.G.; Zhelifonova, V.P.; Antipova, T.V. Fungi of the genus Penicillium as producers of physiologically active compounds (review). Appl. Biochem. Microbiol. 2013, 49, 1–10. [Google Scholar] [CrossRef]
- Nicoletti, R.; Trincone, A. Bioactive compounds produced by strains of Penicillium and Talaromyces of marine origin. Mar. Drugs 2016, 14, 37. [Google Scholar] [CrossRef]
- Yaderets, V.V.; Karpova, N.V.; Glagoleva, E.V.; Ovchinnikov, A.I.; Petrova, K.S.; Dzhavakhiya, V.V. Inhibition of the growth and development of Sclerotinia sclerotiorum (Lib.) de Bary by combining azoxystrobin, Penicillium chrysogenum VKM F-4876D, and Bacillus Strains. Agronomy 2021, 11, 2520. [Google Scholar] [CrossRef]
- Hatem, A.; Karpova, N.V.; Yaderets, V.V.; Glagoleva, E.V.; Petrova, K.S.; Shibaeva, A.S.; Ovchinnikov, A.I.; Dzhavakhiya, V.V. Inhibition of the growth and development of potato early blight pathogen (Alternaria solani) by combining Penicillium chrysogenum VKM F-4876D with some strobilurin-, triazole-, and phenylpyrrole-based fungicides. Agriculture 2022, 12, 1488. [Google Scholar] [CrossRef]
- Tavakkoli, A.; Johnston, T.P.; Sahebkar, A. Antifungal effects of statins. Pharmacol. Ther. 2020, 208, 107483. [Google Scholar] [CrossRef]
- Lefebvre, M.; Alshawa, K.; Dupont, B. Antifungal activity of statins. J. Mycol. Médic. 2010, 20, 212–217. [Google Scholar] [CrossRef]
- Galgóczy, L.; Papp, T.; Lukács, G.; Leiter, E.; Pócsi, I.; Vágvölgyi, C. Interactions between statins and Penicillium chrysogenum antifungal protein (PAF) to inhibit the germination of sporangiospores of different sensitive Zygomycetes. FEMS Microbiol. Lett. 2007, 270, 109–115. [Google Scholar] [CrossRef] [PubMed]
- Astapchuk, I.; Yakuba, G.; Nasonov, A. Efficacy of fungicides against pathogens of apple core rot from the genera Fusarium Link, Alternaria Nees and Botrytis (Fr.) under laboratory conditions. E3S Web Conf. 2021, 285, 03015. [Google Scholar] [CrossRef]
- Maia, J.N.; Beger, G.; Pereira, W.V.; De Mio, L.L.M.; da Silva Silveira Duarte, H. Gray mold in strawberries in the Paraná state of Brazil caused by Botrytis cinerea and its isolates exhibit multiple-fungicide resistance. Crop Prot. 2021, 140, 105415. [Google Scholar] [CrossRef]

Disclaimer/Publisher’s Note: The statements, opinions and data contained in all publications are solely those of the individual author(s) and contributor(s) and not of MDPI and/or the editor(s). MDPI and/or the editor(s) disclaim responsibility for any injury to people or property resulting from any ideas, methods, instructions or products referred to in the content. |
© 2023 by the authors. Licensee MDPI, Basel, Switzerland. This article is an open access article distributed under the terms and conditions of the Creative Commons Attribution (CC BY) license (https://creativecommons.org/licenses/by/4.0/).
Share and Cite
Hatem, A.; Yaderets, V.; Karpova, N.; Glagoleva, E.; Ovchinnikov, A.; Petrova, K.; Shibaeva, A.; Dzhavakhiya, V. Inhibition of the Growth of Botrytis cinerea by Penicillium chrysogenum VKM F-4876D Combined with Fludioxonil-, Difenoconazole-, or Tebuconazole-Based Fungicides. Agronomy 2023, 13, 2602. https://doi.org/10.3390/agronomy13102602
Hatem A, Yaderets V, Karpova N, Glagoleva E, Ovchinnikov A, Petrova K, Shibaeva A, Dzhavakhiya V. Inhibition of the Growth of Botrytis cinerea by Penicillium chrysogenum VKM F-4876D Combined with Fludioxonil-, Difenoconazole-, or Tebuconazole-Based Fungicides. Agronomy. 2023; 13(10):2602. https://doi.org/10.3390/agronomy13102602
Chicago/Turabian StyleHatem, Amjad, Vera Yaderets, Nataliya Karpova, Elena Glagoleva, Alexander Ovchinnikov, Kseniya Petrova, Alexandra Shibaeva, and Vakhtang Dzhavakhiya. 2023. "Inhibition of the Growth of Botrytis cinerea by Penicillium chrysogenum VKM F-4876D Combined with Fludioxonil-, Difenoconazole-, or Tebuconazole-Based Fungicides" Agronomy 13, no. 10: 2602. https://doi.org/10.3390/agronomy13102602
APA StyleHatem, A., Yaderets, V., Karpova, N., Glagoleva, E., Ovchinnikov, A., Petrova, K., Shibaeva, A., & Dzhavakhiya, V. (2023). Inhibition of the Growth of Botrytis cinerea by Penicillium chrysogenum VKM F-4876D Combined with Fludioxonil-, Difenoconazole-, or Tebuconazole-Based Fungicides. Agronomy, 13(10), 2602. https://doi.org/10.3390/agronomy13102602

